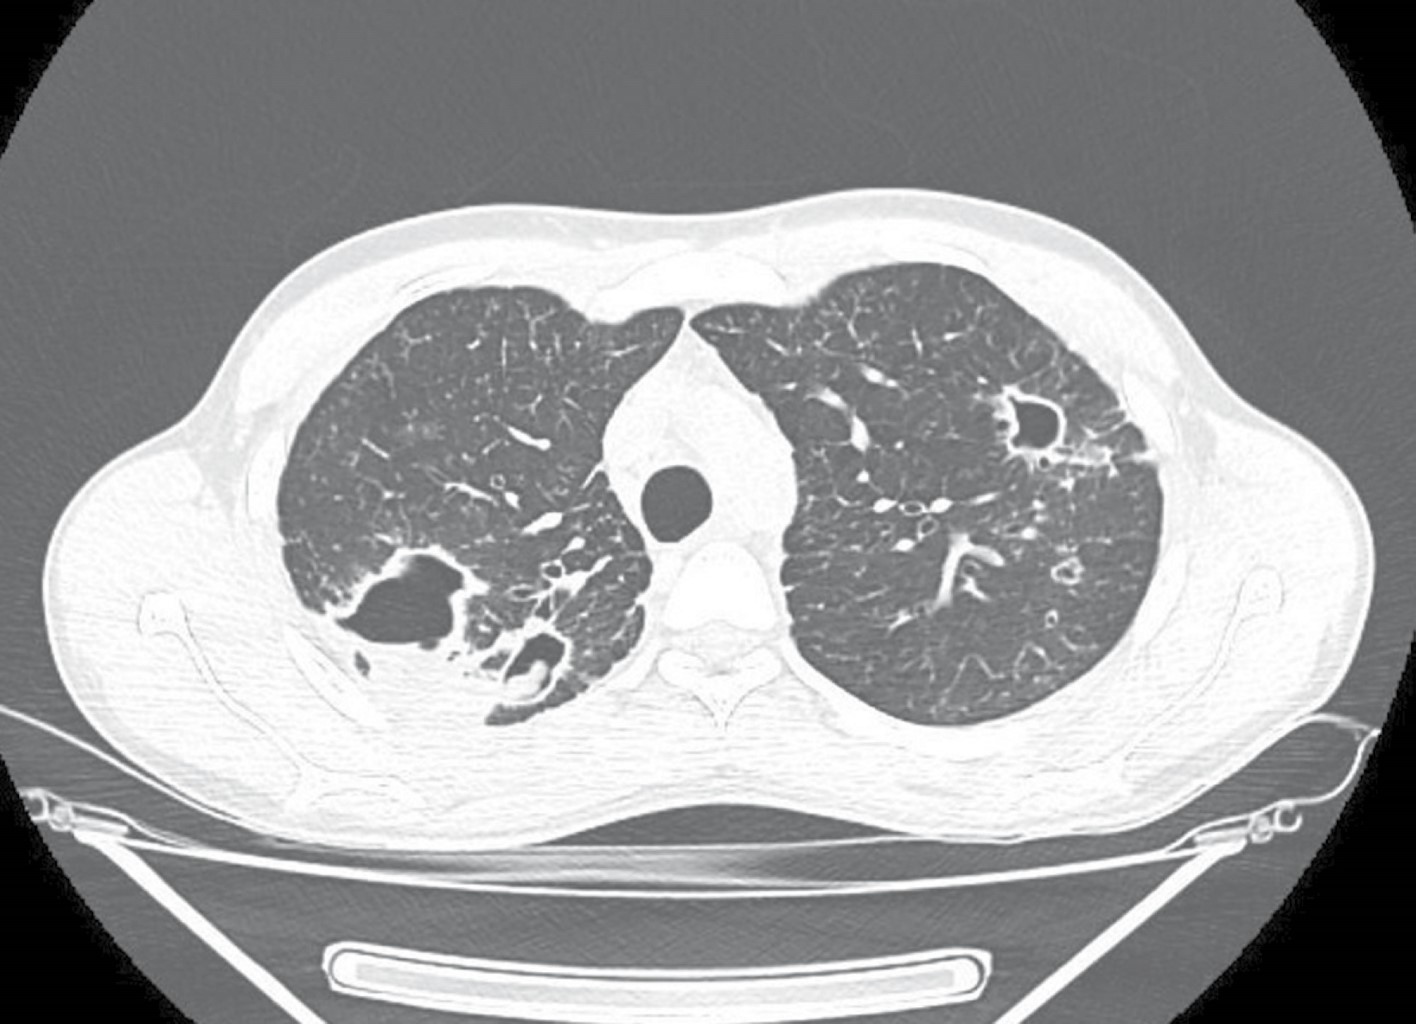

Delayed diagnosis of tuberculosis in a patient with coccidioidomycosis
Rojas-Rojas, Eva Alejandra1; Cinencio-Chávez, Wendy Rosario1; Laniado-Laborín, Rafael1,2
Rojas-Rojas, Eva Alejandra1; Cinencio-Chávez, Wendy Rosario1; Laniado-Laborín, Rafael1,2
ABSTRACT
We present the case of a 24-year-old man from Sonora, residing in Tijuana, Mexico, who referred symptoms of cough and hemoptysis for a year. A chest CT scan showed fibrocavitary lesions, initially suspected to be tuberculosis. Rapid molecular tests did not detect Mycobacterium tuberculosis, while coccidioidomycosis serology was positive and cultures identified Coccidioides spp.; treatment with itraconazole was initiated, but subsequently, the mycobacterial culture was reported as positive for M. tuberculosis, confirming coinfection and antituberculosis treatment was added. The Xpert MTB/RIF test is recommended by the World Health Organization as an initial diagnostic method for tuberculosis due to its high sensitivity and specificity. However, its sensitivity can be low in cases of very low bacillary load, justifying the need for complementary mycobacterial cultures for a thorough diagnosis. In this case, the culture allowed for the detection of tuberculosis despite negative sputum smears and rapid molecular tests, highlighting the importance of phenotypic methods in the diagnosis of tuberculosis. The coinfection of tuberculosis and coccidioidomycosis is a significant diagnostic challenge. The combination of molecular tests and cultures remains essential for an accurate diagnosis and effective treatment, especially in endemic areas for both diseases.KEYWORDS
tuberculosis, coccidioidomycosis, coinfection, Xpert MTB/RIF, mycobacterial culture.Introduction
Coccidioidomycosis is an endemic mycosis of the southwestern United States, northern Mexico, and the rest of Latin America.1 Tuberculosis and coccidioidomycosis share epidemiological, clinical, radiographic, and even histopathological characteristics, making diagnosis difficult when they present simultaneously.2 Additionally, they share some common risk factors, including areas of endemicity and various conditions that cause immunosuppression, such as diabetes and HIV, among others.
Clinical presentation can be similar, with prolonged constitutional symptoms, various respiratory syndromes, and chronic meningitis, years or decades after the initial exposure. Radiographic findings in the chest of patients with chronic pulmonary coccidioidomycosis are virtually identical to those of pulmonary tuberculosis, with the presence of cavitations and fibrous tracts.1
We present a case of pulmonary coinfection in which the rapid molecular test was reported negative for Mycobacterium tuberculosis complex, while coccidioidomycosis was diagnosed through smear, culture, and positive serology. Since all samples from patients suspected of tuberculosis should routinely be cultured, it was also possible to detect, although late, the presence of pulmonary tuberculosis.
Presentation of the case
A 24-year-old male, originally from Sonora and residing in the city of Tijuana sought medical attention for his chronic respiratory symptoms. His clinical history was negative for substance abuse, and he did not report any significant illnesses in the past. Symptoms began a year earlier with cough and hemoptysis. He received private medical care, without a definitive diagnosis, and no information is available on the prescribed treatment. A chest CT showed fibrocavitary lesions in both upper pulmonary lobes, with an intracavitary mass suggestive of mycetoma (Figure 1). Given the suspicion of tuberculosis, a series of sputum smears were requested and later reported as negative, as well as an Xpert MTB/RIF (Mycobacterium tuberculosis complex not detected); as routinely done, a culture for mycobacteria was also processed. Sputum smears reported abundant spherules of Coccidioides spp.; later, a positive culture for Coccidioides spp. was reported, in addition to a positive coccidioidomycosis serology with an IgG titer of 1:64. No evidence of extrapulmonary involvement was detected during the clinical evaluation. Treatment with itraconazole 400 mg daily was started; after two months of treatment, the patient was asymptomatic and had gained 2.7 kg.
Two months later, the culture was reported positive for mycobacteria with a positive rapid chromatographic test for the MTB complex. After dilution, the culture material was examined with the Xpert MTB/RIF Ultra test, confirming the presence of the MTB complex with medium load and without detection of mutations in the rpoB gene associated with rifampicin resistance (susceptible to rifampicin). Treatment with the primary regimen (rifampicin, isoniazid, ethambutol, and pyrazinamide) was initiated and the antifungal regimen was continued.
The patient has currently been discharged as cured from antituberculosis treatment and will continue with antifungal treatment for at least one year according to the initial serology of 1:64, which is considered a marker of disseminated disease.
Discussion
The Xpert MTB/RIF polymerase chain reaction (PCR) test is an automated real-time molecular test for the diagnosis of tuberculosis.3 The World Health Organization (WHO) recommends that this rapid molecular test be used as an initial diagnostic test, replacing sputum smear microscopy due to its higher sensitivity and specificity and that it also offers the advantage of simultaneously providing rifampicin susceptibility.4 However, since there are no genotypic commercial tests for all the drugs used in tuberculosis, phenotypic testing remains necessary at this time as a complement to molecular tests. Additionally, during treatment follow-up, molecular tests are not useful because they require the extraction of mycobacterial DNA with the consequent death of the bacilli; cultures remain the only method available to determine mycobacterial viability.5
While the diagnostic performance of the Xpert MTB/RIF Ultra is far superior to microscopy, false negatives do occur since the sensitivity of the assay varies between 83 and 96%, depending on the bacillary load, and sensitivity under 80% has been reported in patients with negative smears.5 This issue has been partially addressed with the new Ultra cartridges, which have greater sensitivity than the older G4 cartridges. The Xpert MTB/RIF Ultra incorporates two amplification targets for the identification of M. tuberculosis (IS6110 and IS1081) and requires only about 15 colony-forming units (CFUs) for detection versus 116 CFUs for the G4 cartridge. This is partly due to a larger sample volume processed by the Ultra method, which has a reaction chamber with a capacity of 50 vs 25 μL for the G4 cartridge.5,6
Our patient had active tuberculosis and coccidioidomycosis simultaneously at the time of his first consultation at the Tuberculosis Clinic, but his initial sputum smears and Xpert MTB/RIF test were negative. As all samples processed for microscopy and molecular testing are routinely cultured, after eight weeks of observation, the sputum culture was reported as positive for M. tuberculosis.
Conclusions
This case demonstrates the need to include mycobacterial cultures as a backup for molecular tests, as their sensitivity is affected when the bacillary load is very low, and, as mentioned, there are no commercial molecular drug susceptibility tests for all antimycobacterial drugs.
AFILIACIONES
1Autonomous University of Baja California. Tijuana General Hospital, Mexico; 2Sistema Nacional de Investigadores, CONAHCYT.Conflict of interests: the authors do not have any conflict of interests to declare.
REFERENCES
Cadena J, Hartzler A, Hsue G, Longfield RN. Coccidioidomycosis and tuberculosis coinfection at a tuberculosis hospital: clinical features and literature review: clinical features and literature review. Medicine (Baltimore). 2009;88(1):66-76. Available in: http://dx.doi.org/10.1097/MD.0b013e318194757a